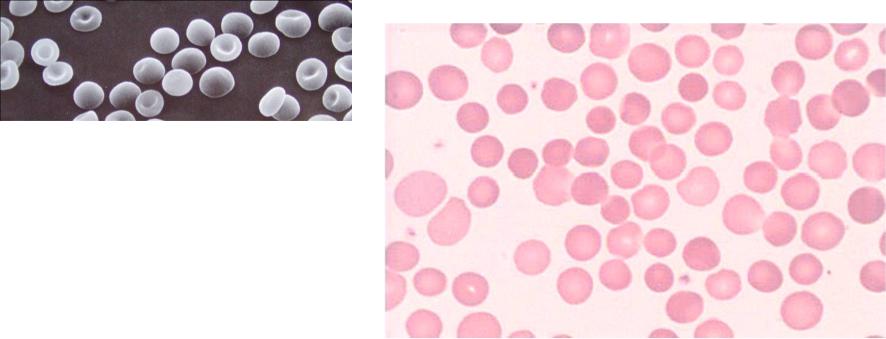

Материал: клинический+анализ+крови+2
Оценка клинического анализа крови
Раздел 2

Нормальные эритроциты
•имеют форму двояковогнутых (biconcav) дисков (Ø 7,5 мкм,
•в световом микроскопе они имеют просветление в центре
•благодаряэластичности и возможностименять форму, свободно проходят через капилляры, имеющие даже меньший диаметр,чем диаметр эритроцита
Так выглядят эритроциты в электронном сканирующем микроскопе (рисунок вверху) и световом микроскопе при окраске по РомановскомуГимзе (рисунок справа)

Классификация анемий
Средний объем эритроцита (MCV)
Микроцитарная |
|
|
|
|
|
Макроцитарная |
|
|
|
Нормоцитарная |
|
|
|
||
(MVC < 80 fL/cell) |
|
|
|
|
(MVC > 100 fL/cell) |
|
|
|
|
(MVC 80-100 fL/cell) |
|
|
|
||
|
|
|
|
|
|
|
|
|
|
|
|
|
|
|
|
|
|
|
|
|
|||
-Железодефицитная |
|
|
-Мегалобластная |
||||
|
Количество |
|
|||||
-Талассемия |
|
|
-B12-дефицитная |
||||
|
ретикулоцитов |
|
|||||
-Анемия хронич. болезней |
|
|
-фолиево-дефицитная |
||||
|
|
|
|||||
-Сидеробластная |
|
|
|
-алкогольная болезнь печени |
|||
|
|
|
|
|
|
|
|
Низкое
-Гипопластическая -Апластическая
-Миелофиброз -Лейкоз
-Почечная недостаточность
-Анемия хронич. болезней
Высокое
-Серповидно-клеточная -Наследств.сфероцитоз -аутоиммуннаягемолитическая
-Пароксизмальная ночная гемоглобинурия - Дефицит глюкозо 6 фосфат дегидгогеназы

Изменения размера (анизоцитоз) и формы (пойкилоцитоз) эритроцитов
Эллиптоцитоз– овалоцитоз является вариантом пойкилоцитоза.
•Наследуется аутосомно-доминантно. Клинико-лабораторная картина гемолитической анемии развивается обычно при количестве овальных (эллипсоидных) клеток более 25%.
•Овалоциты в небольшом проценте могут встречаться у здоровых людей
Так выглядят эритроциты в электронном сканирующем микроскопе (рисунок вверху) и световом микроскопе при окраске по РомановскомуГимзе (рисунок справа)
Некоторые эритроциты не имеют центрального просветления
Изменения размера (анизоцитоз) и формы (пойкилоцитоз) эритроцитов
Наследственный сфероцитоз
•Гемолитическая анемия с аутосомно-доминантным наследованием
•Гемолиз происходит в селезёнке, которая увеличивается
•Течение нередко кризовое с массивным гемолизом и последующим высоким ретикулоцитозом
•Имеется склонность к образованию билирубиновых камней
Зрелые эритроциты имеют небольшой размер (микроциты по диаметру), но нормальный объём (нормоциты по объёму), центральное просветление отсутствует